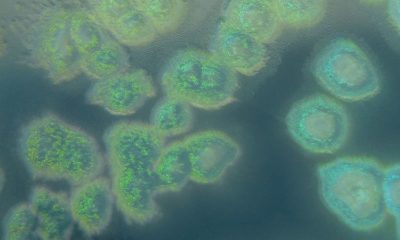

Un prêtre ayant prononcé une oraison funèbre pour l'opposant Alexeï Navalny le mois dernier ne pourra plus conduire d'office religieux pendant 3 ans. C'est ce qu'indique un décret signé par le chef de l'Église orthodoxe publié sur le site du Patriarcat de Moscou.
Outre cette interdiction, le prêtre, Dimitri Safronov, ne peut plus "porter la soutane et la croix", peut-on lire dans ce décret signé par le patriarche Kirill le 15 avril.
Dimitri Safronov, qui officiait jusque-là dans une église du centre de Moscou, exercera désormais les fonctions de sacristain dans une autre église de la capitale russe, selon ce décret, qui ne précise pas les raisons de cette sanction.
"Les raisons de l'interdiction ne sont pas indiquées dans le document (mais nous comprenons bien pourquoi)", a écrit l'équipe de Navalny dans un communiqué partagé mardi sur Telegram.
Selon les partisans d'Alexeï Navalny, Dimitri Safronov avait prononcé cette oraison funèbre le 26 mars, soit 40 jours après la mort de l'opposant, conformément à la tradition orthodoxe. Le service s'était déroulé en présence de la famille et de sympathisants de l'opposant, au cimetière moscovite de Borissovo où Alexeï Navalny est enterré.
Autorités accusées de meurtre
Alexeï Navalny, principal ennemi politique du Kremlin, est mort le 16 février dans des circonstances restées troubles, dans une prison de l'Arctique où il était soumis à des conditions de détention particulièrement sévères. Les autorités russes ont affirmé qu'il était mort de causes naturelles, mais les proches de l'opposant les accusent de meurtre.
La répression des voix dissidentes en Russie s'est considérablement accrue depuis le début de l'offensive russe en Ukraine. Des milliers de Russes ont été arrêtés pour avoir manifesté leur désaccord avec l'offensive et des centaines d'entre eux ont été condamnés à des peines de prison.
La quasi-totalité des opposants d'envergure sont derrière les barreaux ou en exil à l'étranger.
Cet article a été publié automatiquement. Sources : ats / blg / afp